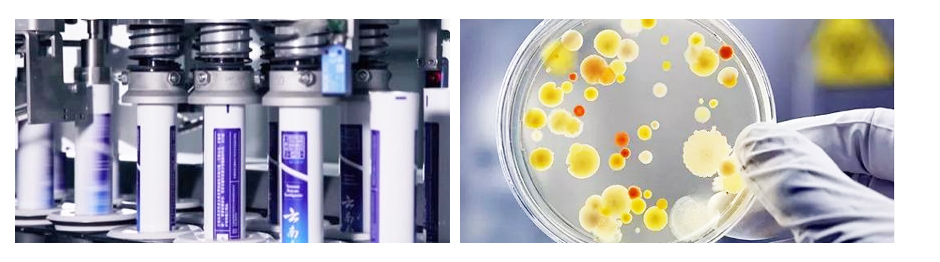

牙膏生產(chǎn)純水設(shè)備解決方案
- 來源:
- 君浩環(huán)保集團(tuán)
- 瀏覽:
- 2879
- 發(fā)布日期:
- 2023-06-24
使用純水設(shè)備的好處



產(chǎn)品特點(diǎn):
1.去除懸浮顆粒和沉淀 2.除去溶解性離子 3.去除氣體 4.防止膜堵塞,保護(hù)RO膜 5.可降低能耗,節(jié)約資源

產(chǎn)品特點(diǎn):
1.去除溶解性離子 2.去除微生物和病毒 3.提高水質(zhì) 4.保障產(chǎn)水的穩(wěn)定性 5.降低企業(yè)生產(chǎn)成本
牙膏是一種直接用于口腔的產(chǎn)品,水的純凈度對(duì)產(chǎn)品質(zhì)量至關(guān)重要。使用純水設(shè)備可以去除水中的雜質(zhì)、溶解物和微生物,確保牙膏的質(zhì)量純凈。這有助于避免水中污染物對(duì)牙膏質(zhì)量的影響,提供更好的清潔效果和口腔護(hù)理效果。
 生產(chǎn)用水標(biāo)準(zhǔn)
生產(chǎn)用水標(biāo)準(zhǔn)
生產(chǎn)牙膏標(biāo)準(zhǔn)符合GB8372-2008
1. 微生物指標(biāo):
菌落總數(shù)(cfu/g):≤500
霉菌與酵母菌總數(shù) (cfu/g):≤100
糞大腸菌群/g :不得檢出
銅綠假單胞菌/g :不得檢出
金黃色葡萄球菌/g 不得檢出
2.有毒物質(zhì)限量
鉛(Pb)含量(mg/kg:≤15
砷(As)含量(mg/kg): ≤5
3.感官指標(biāo)
膏體 均無、無異物
4.理化指標(biāo)
PH值:5.5 ~ 10.0
穩(wěn)定性: 膏體不溢出管口,不分離出出液體,香味色澤正常
過硬顆粒:玻片無劃痕
可溶氟或游離氟量:0.05-0.15(適用于含氟牙膏) 0.05-0.11(適用于兒童含氟牙膏)
總氟量:0.05-0.15(適用于含氟牙膏) 0.05-0.11(適用于兒童含氟牙膏)
可根據(jù)客戶需求定制,出水達(dá)行業(yè)用水標(biāo)準(zhǔn)











 陜公網(wǎng)安備 61040202000640號(hào)
陜公網(wǎng)安備 61040202000640號(hào)